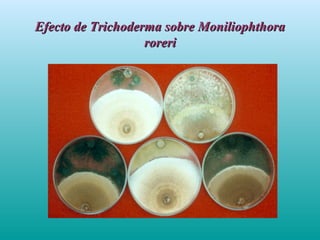
Efecto de Trichoderma sobre MoniliophthoraEfecto de Trichoderma sobre Moniliophthora
roreriroreri
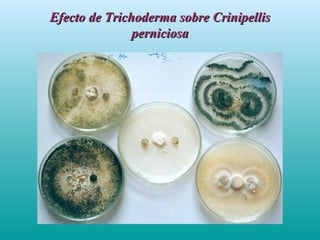
Efecto de Trichoderma sobre CrinipellisEfecto de Trichoderma sobre Crinipellis
perniciosaperniciosa
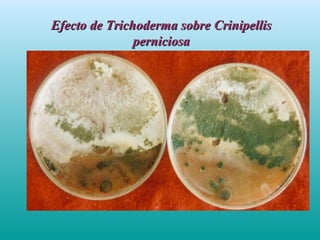
Efecto de Trichoderma sobre CrinipellisEfecto de Trichoderma sobre Crinipellis
perniciosaperniciosa

Este documento resume un curso de capacitación sobre control biológico impartido en el Instituto de Cultivos Tropicales. Explica los diferentes tipos de control biológico como entomopatógenos, parasitoides y depredadores, y ofrece ejemplos de su uso contra plagas como la broca del café y el gorgojo negro del plátano utilizando hongos como Beauveria bassiana y Metarrhizium. También cubre la cría y liberación de parasitoides, y el control biológico de enfermedades con Trichoder